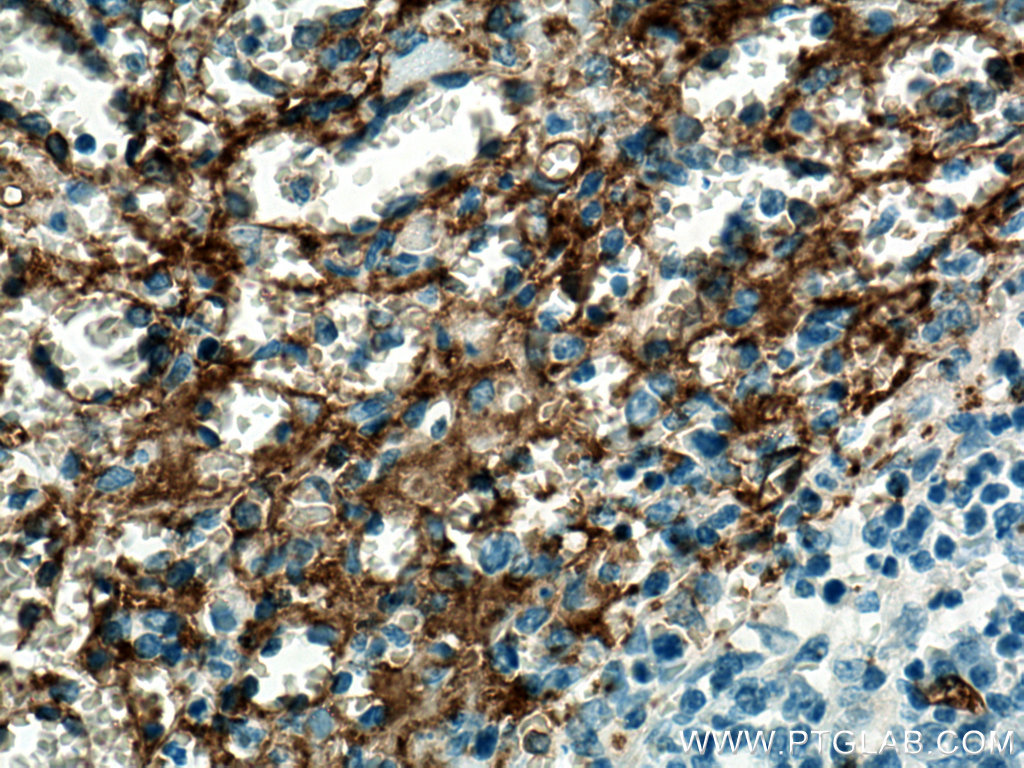
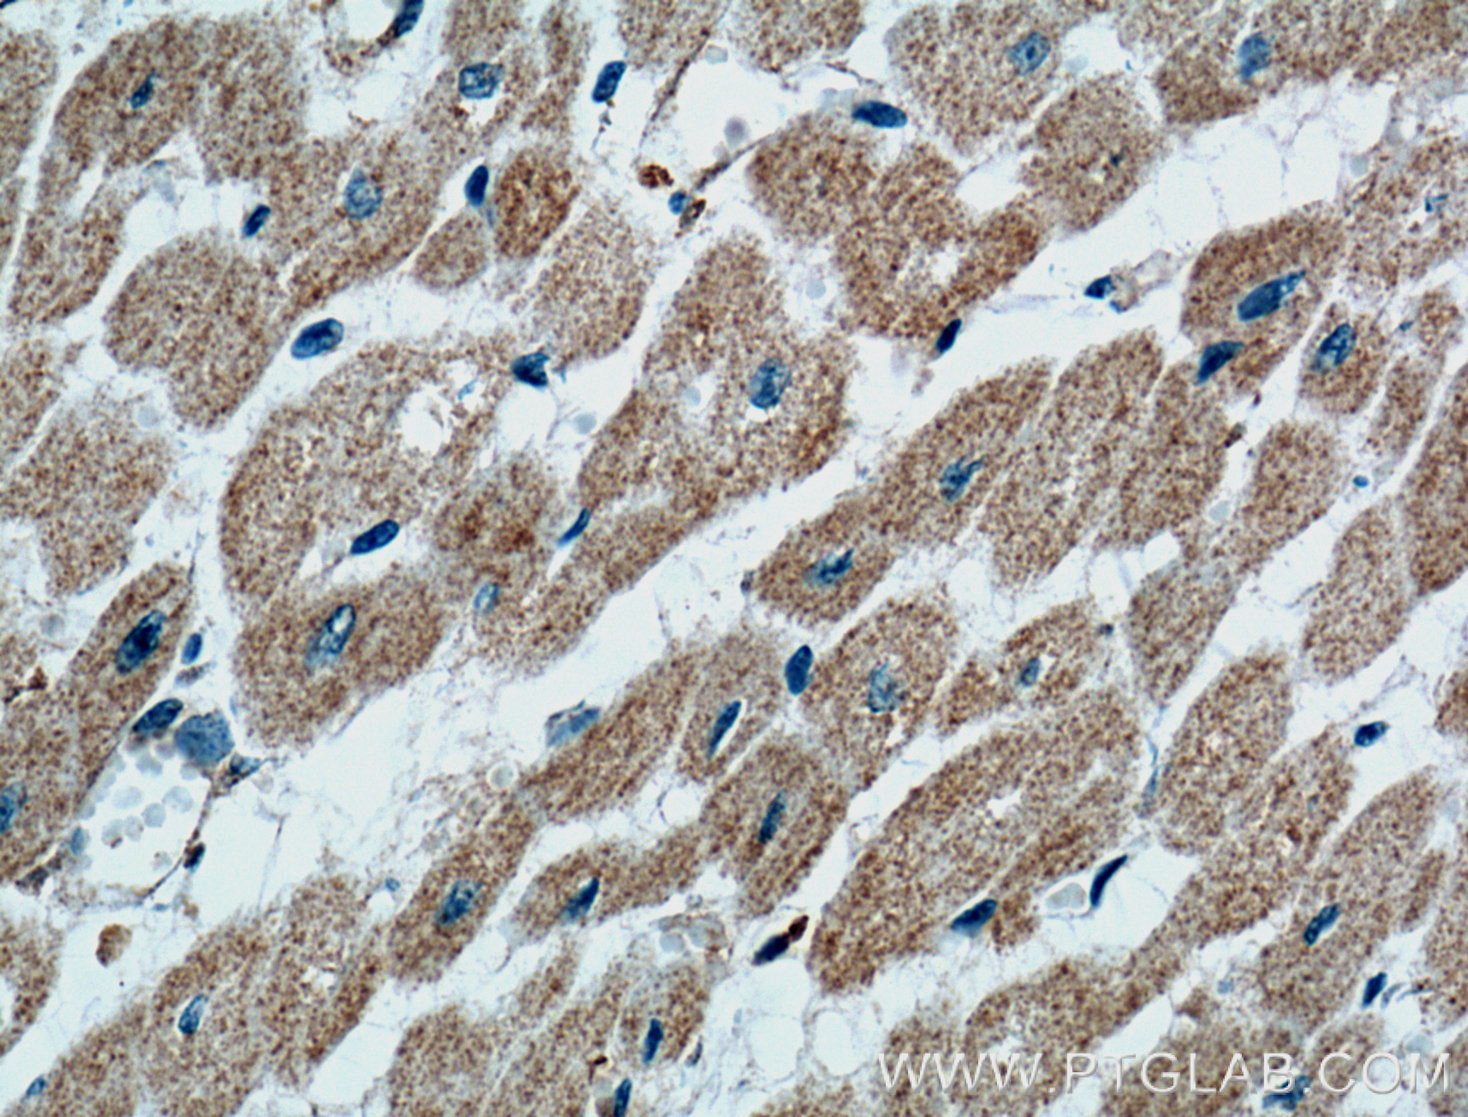

验证数据展示
经过测试的应用
| Positive WB detected in | human heart tissue, human milk, human spleen tissue, human placenta tissue |
| Positive IHC detected in | human spleen tissue, human heart tissue Note: suggested antigen retrieval with TE buffer pH 9.0; (*) Alternatively, antigen retrieval may be performed with citrate buffer pH 6.0 |
| Positive IF-P detected in | human liver cancer tissue, THP-1 cells |
| Positive IF/ICC detected in | THP-1 cells |
推荐稀释比
| 应用 | 推荐稀释比 |
|---|---|
| Western Blot (WB) | WB : 1:1000-1:6000 |
| Immunohistochemistry (IHC) | IHC : 1:500-1:2000 |
| Immunofluorescence (IF)-P | IF-P : 1:200-1:800 |
| Immunofluorescence (IF)/ICC | IF/ICC : 1:400-1:1600 |
| It is recommended that this reagent should be titrated in each testing system to obtain optimal results. | |
| Sample-dependent, Check data in validation data gallery. | |
产品信息
66395-1-Ig targets CD36 in WB, IHC, IF/ICC, IF-P, IP, ELISA applications and shows reactivity with human samples.
| 经测试应用 | WB, IHC, IF/ICC, IF-P, ELISA Application Description |
| 文献引用应用 | WB, IHC, IF, IP |
| 经测试反应性 | human |
| 文献引用反应性 | human |
| 免疫原 |
CatNo: Ag13541 Product name: Recombinant human CD36 protein Source: e coli.-derived, PET28a Tag: 6*His Domain: 1-472 aa of BC008406 Sequence: MGCDRNCGLIAGAVIGAVLAVFGGILMPVGDLLIQKTIKKQVVLEEGTIAFKNWVKTGTEVYRQFWIFDVQNPQEVMMNSSNIQVKQRGPYTYRVRFLAKENVTQDAEDNTVSFLQPNGAIFEPSLSVGTEADNFTVLNLAVAAASHIYQNQFVQMILNSLINKSKSSMFQVRTLRELLWGYRDPFLSLVPYPVTTTVGLFYPYNNTADGVYKVFNGKDNISKVAIIDTYKGKRNLSYWESHCDMINGTDAASFPPFVEKSQVLQFFSSDICRSIYAVFESDVNLKGIPVYRFVLPSKAFASPVENPDNYCFCTEKIISKNCTSYGVLDISKCKEGRPVYISLPHFLYASPDVSEPIDGLNPNEEEHRTYLDIEPITGFTLQFAKRLQVNLLVKPSEKIQVLKNLKRNYIVPILWLNETGTIGDEKANMFRSQVTGKINLLGLIEMILLSVGVVMFVAFMISYCACRSKTIK 种属同源性预测 |
| 宿主/亚型 | Mouse / IgG1 |
| 抗体类别 | Monoclonal |
| 产品类型 | Antibody |
| 全称 | CD36 molecule (thrombospondin receptor) |
| 别名 | GPIV, GPIIIB, GP4, GP3B, Glycoprotein IIIb |
| 计算分子量 | 472 aa, 53 kDa |
| 观测分子量 | 88 kDa |
| GenBank蛋白编号 | BC008406 |
| 基因名称 | CD36 |
| Gene ID (NCBI) | 948 |
| RRID | AB_2811030 |
| 偶联类型 | Unconjugated |
| 形式 | Liquid |
| 纯化方式 | Protein G purification |
| UNIPROT ID | P16671 |
| 储存缓冲液 | PBS with 0.02% sodium azide and 50% glycerol, pH 7.3. |
| 储存条件 | Store at -20°C. Stable for one year after shipment. Aliquoting is unnecessary for -20oC storage. |
背景介绍
Function
CD36, also known as platelet glycoprotein 4, is an integral membrane glycoprotein that acts as a scavenger receptor. CD36 can bind to multiple ligands, including thrombospondin-1, collagen, oxidized phospholipids, oxidized low-density lipoprotein, and long-chain fatty acids. CD36 can also bind to erythrocytes parasitized by Plasmodium falciparum and apoptotic cells. CD36 mediates different biological processes, acting as a signaling hub in angiogenesis, inflammatory response, and fatty acid metabolism.
Tissue specificity
CD36 is present on the surface of various cells types, such as adipocytes, monocytes, macrophages, platelets, microvascular endothelial cells, dendritic cells, and hematopoietic precursors of red cells.
Involvement in disease
-
Mutations in CD36 can give rise to platelet glycoprotein IV deficiency, a type of macrothrombocytopenia.
-
Polymorphisms in CD36 can increase susceptibility to malaria.
-
AAGIC haplotype at the CD36 locus increases the risk of coronary heart disease.
-
Disruption of CD36-dependent pathways and certain SNPs in the CD36 gene are attributed to impaired fatty acid metabolism, glucose intolerance, Alzheimer's disease, atherosclerosis, arterial hypertension, diabetes, and cardiomyopathy.
Isoforms
Apart from the full-length protein (isoform 1), one additional shorter isoform has been reported (PMID: 7509795). Other alternative isoforms have also been detected on the mRNA level (PMID: 17673938).
Post-translational modifications
The extracellular domain of CD36 is extensively glycosylated. Glycosylation is needed for the transport of CD36 to the plasma membrane, as well as mediating recognition and binding to ligands. Cytoplasmic tails of transmembrane domains can be phosphorylated and play a role in signal transduction. Intracellular domains can be additionally acetylated, ubiquitinated, and palmitoylated (PMID: 28919632).
Cellular localization
CD36 is present on the cell surface.
实验方案
| Product Specific Protocols | |
|---|---|
| IF protocol for CD36 antibody 66395-1-Ig | Download protocol |
| IHC protocol for CD36 antibody 66395-1-Ig | Download protocol |
| WB protocol for CD36 antibody 66395-1-Ig | Download protocol |
| Standard Protocols | |
|---|---|
| Click here to view our Standard Protocols |
发表文章
| Species | Application | Title |
|---|---|---|
Cell Metab Targeting Erbin-mitochondria axis in platelets/megakaryocytes promotes B cell-mediated antitumor immunity | ||
Oxid Med Cell Longev Idol Depletion Protects against Spontaneous Atherosclerosis in a Hamster Model of Familial Hypercholesterolemia. | ||
Int J Biol Sci LAMC1-mediated preadipocytes differentiation promoted peritoneum pre-metastatic niche formation and gastric cancer metastasis. | ||
Cells The Exocyst Is Required for CD36 Fatty Acid Translocase Trafficking and Free Fatty Acid Uptake in Skeletal Muscle Cells | ||
Food Funct CD36 and DGAT2 facilitate the lipid-lowering effect of chitooligosaccharides via fatty acid intake and triglyceride synthesis signaling. |